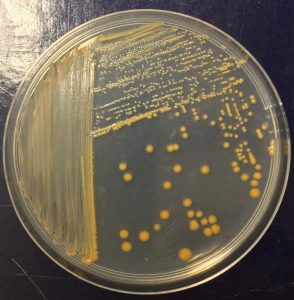
IBB-BSRG_958A9BCB-3854-46A0-A76A-362E96D28087

Biological Sciences Research Group
Through advanced research methodologies, we aim to uncover new insights and advance scientific understanding in Biological Sciences, directly impacting Health and driving progress in the Bioeconomy.
Keywords
Functional / Comparative and Meta-Genomics
Microbial Pathogenesis
Applied and Environmental Microbiology
Molecular and Cellular Biology
Coordinator
Goals
The Biological Sciences Research Group (BSRG)
BSRG conducts research in fundamental and applied biological sciences. Research projects combine Microbiology, Molecular and Cellular Biology, Biochemistry, Functional and Comparative Genomics, Metagenomics, and Bioinformatics approaches. Systems and Synthetic Microbiology strategies are also used envisaging the understanding of how biological systems orchestrate multiple and complexfunctions and the effective control or exploitation of their activities relevant for Human Health and Bioeconomy.
Focus Areas
People
The BSRG Team
Coordinator
For applications or further information, please get in touch!